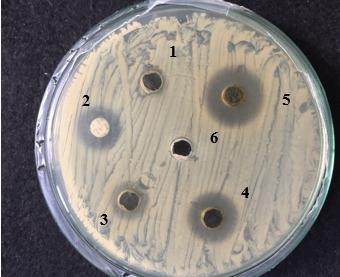
Hình 4 9 Giá trị MIC của cao chiết lá Trứng cá ức chế vi khuẩn P acnes Ghi chú 1 1

là DMSO và đối chứng dương là levofloxacin (5µg/ml). Nồng độ ức chế tối thiểu là nồng độ thấp nhất mà tại đó xuất hiện vòng vô khuẩn nên nồng độ ức chế tối thiểu càng thấp thì khả năng kháng khuẩn càng cao.
Bảng 4.4. Kết quả nồng độ ức chế vi khuẩn tối thiểu (MIC) của cao chiết lá Trứng cá đối với vi khuẩn P. acnes.
Đường kính vòng vô khuẩn (mm) | |
40 | 11 ± 1 |
20 | 9 ± 1 |
10 | 6 ± 0 |
5 | - |
Có thể bạn quan tâm!
-
Tình Hình Nghiên Cứu Và Ứng Dụng Cao Chiết Từ Cây Trứng Cá Trong Và Ngoài Nước -
Nuôi Cấy Và Nhận Diện Dòng Vi Khuẩn Propionibacterium Acnes -
Nuôi Cấy Và Nhận Diện Vi Khuẩn Propionibacterium Acnes -
Khảo sát khả năng ức chế vi khuẩn gây bệnh mụn trứng cá Propionibacterium acnes của cao chiết từ cây Trứng cá Muntingia calabura L. - 8 -
Khảo sát khả năng ức chế vi khuẩn gây bệnh mụn trứng cá Propionibacterium acnes của cao chiết từ cây Trứng cá Muntingia calabura L. - 9 -
Khảo sát khả năng ức chế vi khuẩn gây bệnh mụn trứng cá Propionibacterium acnes của cao chiết từ cây Trứng cá Muntingia calabura L. - 10
Xem toàn bộ 89 trang tài liệu này.
Ghi chú: kết quả ± với độ lệch chuẩn của từng giá trị. (-) là không kháng khuẩn
Hình 4.9. Giá trị MIC của cao chiết lá Trứng cá ức chế vi khuẩn P. acnes
Ghi chú: (1) nồng độ 5 mg/ml; (2) đối chứng dương levofloxacin; (3) nồng độ 10
mg/ml; (4) nồng độ 20 mg/ml; (5) nồng độ 40 mg/ml; (6) đối chứng âm DMSO.
Nhận xét: ở nồng độ 40 mg/ml cao chiết có khả năng ức chế vi khuẩn P. acnes với vòng vô khuẩn đạt 11 ± 1 mm. Nồng độ 20 mg/ml vòng vô khuẩn đạt 9 ± 1 mm Nồng độ 10 mg/ml vòng vô khuẩn đạt 6 ± 0 mm. Nồng độ 5 mg/ml không quan sát thấy hiệu quả kháng khuẩn của cao chiết lá trứng cá vòng vô khẩn bằng 0 mm.
Từ kết quả ta thấy nồng độ 10 mg/ml là nồng độ thấp nhất của cao chiết lá trứng cá có khả năng ức chế vi khuẩn P.acnes.
4.1.5. Định tính một số hợp chất thiên nhiên trong cao chiết từ lá Trứng cá
Để đánh giá sơ bộ thành phần hóa học trong cao chiết ethanol, tiến hành định tính một số hợp chất có hoạt tính sinh học như flavonoid và saponin, tanin. Kết quả được trình bày ở bảng 4.5

Bảng 4.5. Kết quả định tính một số hợp chất trong dịch chiết ethanol của lá Trứng cá
Hiện tượng | Kết quả | Hình | |
Flavonoid | Dung dịch màu đỏ | + |
|
Saponin | Xuất hiện bọt | + | 1 2 |
Tanin | Dung dịch màu xanh đen | + |
|
Ghi chú: +: kết quả dương tính; 1: mẫu thử; 2: mẫu chứng.
4.2. THẢO LUẬN
4.2.1. Chiết cao
Độ ẩm nguyên liệu khô lá Trứng cá (12,8 %) và vỏ thân cây Trứng cá (13 %) dưới 13 % đạt mức độ ẩm an toàn dược liệu theo tiêu chuẩn DĐVN IV.Việc xác định độ ẩm của mẫu khô trước khi tiến hành chiết xuất giúp biết được các điều kiện để xác định phương pháp chiết xuất phù hợp, nhằm thu được lượng cao chiết tối ưu. Ngoài ra, việc xác định độ ẩm của nguyên liệu còn tạo điều kiện để xác định nhiệt độ và thời gian sấy mẫu thích hợp để tiến hành chiết xuất có hiệu suất cao hơn theo Dương Phượng Liên và Nguyễn Nhật Minh Phương (2014) trong suốt quá trình sấy mẫu, nhiệt độ cao làm phá vỡ các cấu trúc tế bào bên trong của nguyên liệu, tạo điều kiện cho dung môi và nguyên liệu tiếp xúc tốt hơn, tăng hiệu suất chiết. Bên cạnh đó, quá trình sấy còn có tác dụng làm giảm độ ẩm của nguyên liệu giúp tăng tỷ lệ dung môi sử dụng với nguyên liệu.
Để đánh giá hiệu quả của phương pháp chiết, người ta thường dựa trên hiệu suất cao chiết. Hiệu suất chiết cao phản ánh sự tối ưu của việc kết hợp các điều kiện khác nhau trong phương pháp chiết. Kết quả hiệu suất chiết các lá, vỏ thân, quả non và quả chín với dung môi ethanol 96% bằng phương pháp đun hồi lưu lần lượt là 43,34 %; 33,27
%; 34,05 % và 24,82 % (so với khối lượng khô). Các kết quả hiệu suất chiết cao lá cao hơn so với nghiên cứu (Puguh et al., 2014) bằng phương pháp ngâm với dung môi ethanol hiệu suất chiết là 9,572 %, bên cạnh đó hiệu suất chiết cao nước là 11,928 % cao hơn khi chiết bằng ethanol. Nguyên nhân những khác biệt do phương pháp đun hồi lưu gia tăng hiệu quả hòa tan các hợp chất có hoạt tính sinh học tốt hơn nên cho hiệu quả cao chiết cao hơn phương pháp ngâm. Hiệu suất chiết còn bị ảnh hưởng bởi các điều kiện khác nhau như nhiệt độ, thời gian sấy mẫu, mẫu thu hái những vùng khác nhau, thời gian thu hái khác nhau, loại dung môi. Độ chín của cấu tạo tế bào quả trứng cá ảnh hưởng quá trình chiết, mức độ phá vỡ mô tế bào một nhân tố cơ bản đẩy nhanh và làm triệt để tiến hành chiết xuất bởi dung môi, làm giải phóng nhiều chất hơn.
4.2.2. Phân lập và nhận diện vi khuẩn
Qua kết quả thí nghiệm kiểm tra một số đặc điểm hình thái và sinh hoá của dòng vi khuẩn phân lập cho thấy những đặc điểm sau:
- Trên môi trường TYEG agar có bổ sung 0,002 % bromocresol purple sau 72 giờ khuẩn lạc có hình dạng tròn, bìa nguyên, nhô cao hoàn toàn trên môi trường, màu vàng đậm .
- Tế bào hình que, Gram dương, catalase dương tính, tạo indol từ trytophan, phản ứng phản nitrat hóa và làm dịch hóa gelatin.
Những đặc điểm này phù hợp với công bố của Kishishita et al., 1980; Higaki et al., 2004 về đặc điểm của loài P. acnes. Theo Kishishita et al., 1980; Higaki et al., 2004
P. acnes có khuẩn lạc hình tròn, bìa nguyên, nhô cao hoàn toàn, màu vàng nhạt hoặc đậm trên môi trường TYEG agar có bổ sung 0,002 % bromocresol purple (khuẩn lạc phát triển chậm). Trong điều kiện kỵ khí tế bào hình que, Gram dương, không sinh bào tử. Vi khuẩn P. acnes có khả năng sản xuất nitrat, catalase và indol dương tính, dịch hóa gelatin.
Các loài giống Propionibacterium hiện diện trên da khác như: Propionibacterium avidum, Propionibacterium granulosum có những đặc điểm chung của giống Propionibacterium như khuẩn lạc có dạng tròn, bìa nguyên, mô, tế bào hình que, Gram dương và catalase dương tính. Ngoài ra các loài trong giống Propionibacterium có những đặc điểm khác biệt như: trên môi trường TYEG agar có bổ sung 0.002% bromocresol purple, loài P. granulosum có màu nâu khuẩn lạc to (2 - 3mm). Cả hai loài P. avidum và P. granulosum không tạo được indol từ tryptophan.
Vì vậy có thể kết luận rằng dòng vi khuẩn 134N từ nghiên cứu “ Khảo sát tình hình đề kháng kháng sinh của vi khuẩn gây mụn trứng cáPropionibacterium acnes tại thành phố Cần Thơ” của Phạm Thị Tường Vy (2017) được lưu tại phòng thí nghiệm Vi sinh trường Đại học Tây Đô là vi khuẩn Propionibacterium acnes.
4.2.3. Khảo sát khả năng ức chế vi khuẩn Propionibacterium acnes của cao chiết cây trứng cá
Khảo sát khả năng ức chế dòng vi khuẩn 134N của các bộ phận cây Trứng cá cho thấy cao Trứng cá chiết bằng dung môi ethanol 96 % ở các nồng độ 200 mg/ml; 100 mg/ml và 50 mg/ml đều có khả năng ức chế dòng vi khuẩn 134N với kích thước khoảng vô khuẩn dao động từ 10,33 mm đến 23 mm. Cây Trứng cá có tiềm năng kháng khuẩn vi khuẩn P. acnes trên các bệnh nhân trứng cá. Hiệu quả kháng khuẩn của cao chiết cây Trứng cá có khả năng kháng khuẩn là do chứa các hợp chất flavonoid. Theo Cushnie
và Andrew (2005) hầu hết các hợp chất flavonoid có tác dụng kháng khuẩn do: kiềm
hãm và ngăn sự phân chia của vi khuẩn, ức chế enzym transpeptidase ngăn quá trình tổng hợp mucopeptid (yếu tố tạo sự bền vững của thành vi khuẩn); khi gắn lên màng vi khuẩn làm thay đổi tính thấm của màng; ức chế quá trình tổng hợp acid nucleic và RNA của vi khuẩn và ức chế hoạt động của hyaluronidase (enzym giúp vi khuẩn tấn công sang các tế bào lân cận)
Kích thước khoảng vô khuẩn càng tăng khi nồng độ cao càng tăng cho thấy nồng độ cao sẽ tỷ lệ thuận với kháng khuẩn của cao. Ở từng nồng độ, cao Trứng cá tạo khoảng vô khuẩn với dòng vi khuẩn 134N có sự khác biệt ý nghĩa thống kê mức 5 %. Trong các nồng độ 200 mg/ml; 100 mg/ml và 50 mg/ml cao chiết từ lá trứng cá có kích thước khoảng vô khuẩn trung bình ở từng nồng độ lần lượt là 23 ± 1,732 mm; 19 ± 0,000 mm; 16,33 ± 2,082mm cho thấy khả năng kháng khuẩn dòng vi khuẩn 134N ở cao lá Trứng cá là cao nhất so với các loại cao còn lại. Kết quả kháng khuẩn dòng 134N ở cao chiết từ lá trứng cá nồng độ 200 mg/ml (khoảng vô khuẩn đường kính bằng 23 ± 1,732 mm) cao hơn với nghiên cứu của Sukatta et al., 2010 trên cao chiết vỏ trái chôm chôm (khoảng vô khuẩn đường kính bằng 18,83 ± 0,98 mm) và gần với kết quả cao chiết vỏ trái măng cụt khả năng kháng P. acnes với đường kính khoảng vô khuẩn 23,83 ± 0,98 mm cứu của Sukatta et al., 2010.
Các nồng độ cao Trứng cá đều có khoảng vô khuẩn lớn hơn so với kháng sinh đối chứng levofloxacin, cho thấy khả năng ức chế dòng vi khuẩn 134N của cao Trứng cá chiết bằng dung môi ethanol 96 % cao hơn kháng sinh đối chứng. Sự đề kháng của vi khuẩn P. acnes với các loại kháng sinh ngày càng gia tăng do sự lạm dụng sử dụng thuốc kháng sinh trong điều trị bệnh trứng cá trong thời gian kéo dài (Nguyễn Thanh Hùng và Nguyễn Tất Thắng, 2013). Theo 2 nghiên cứu của Ross et al., 2001 và Ross et al., 2002 đột biến gen 16S và 23S rRNA chính là nguyên nhân gây ra việc đề kháng của P. acnes đối với các loại kháng sinh. Đặc biệt các kháng sinh như erythromycin và clindamycin tỷ lệ đề kháng càng gia tăng. Sự đề kháng kháng sinh nhóm fluoroquinolon (ciprofloxacin, levofloxacin..) đã được báo cáo gần đây với tỷ lệ đề kháng 9,6 % tại Ấn độ năm 2016 (Kabir et al., 2016).
4.2.4. Xác định nồng độ ức chế tối thiểu của cao lá Trứng cá trên vi khuẩn
Propionibacterium acnes
Nồng độ tối thiểu ức chế sự phát triển của vi khuẩn P. acnes của cao chiết từ lá cây
Trứng cá là 10 mg/ml. Nhiều nghiên cứu khác của lá cây Trứng cá có khả năng ức chế 43
vi khuẩn gây bệnh, theo Yasunaka (2005) cho rằng hoạt tính khác khuẩn của cao chiết lá Trứng cá được xác định bằng nồng độ ức chế tối thiểu (MIC) chống lại vi khuẩn gây bệnh như Escherichia coli (C600) và Staphyloccocus aureus (209 P) có nồng độ lần lượt là 512 µg/ml và 1024 µg/ml.
Hoạt tính kháng khuẩn của cao lá Trứng cá so sánh với các loại cao chiết khác trên cùng vi khuẩn P. acnes thông qua giá trị MIC. Giá trị MIC (10 mg/ml) trong thí nghiệm này cao hơn so với một số thực vật khác đã được công bố. Theo Kumar et al., 2007 dịch chiết hoa Lài trong dung môi ethanol ức chế vi khuẩn P. acnes với giá trị MIC là 5 mg/ml. Hay ở nghiên cứu khác của Fu et al., 2007 tinh dầu hoa Hương thảo (Rosmarinus offcinalis L.) hoạt tính kháng P. acnes có giá trị MIC 0,56 mg/ml. Dịch chiết nước từ E. cochinchinesis và S. offcinalis hoạt tính kháng P. acnes có giá trị MIC lần lượt là 1,56 mg/ml và 6,25 mg/ml. Mặc khác khả năng kháng khuẩn của cao chiết lá Trứng cá cao hơn so với cao chiết ethyl acetat lá Ô môi có giá trị MIC = 30 mg/ml (Phùng Thị Yến Thanh, 2015)
Trong thí nghiệm thực hiện, khảo sát hoạt tính kháng P. acnes của dịch chiết được tiến hành trên một dòng vi khuẩn không có sự khảo sát khả năng chống chịu của dòng vi khuẩn và kháng với kháng sinh levofloxacin là kháng sinh phổ kháng khuẩn rộng; điều này có thể giải thích tại sao khả năng kháng P. acnes của cao chiết ethanol lá Trứng cá này cao hơn so nghiên cứu khác. Mặc khác, giá trị MIC của cao chiết lá Trứng cá cao hơn so với các công bố trước là so phương pháp chiết xuất khác nhau, thành phần hoạt chất có trong các loài khác nhau và sử dụng loại dung môi khác nhau.
4.2.5. Định tính một số hợp chất thiên nhiên trong cao chiết ethanol lá Trứng cá
Kết quả phân tích định tính cho thấy trong cao chiết dịch chết ethanol của lá Trứng cá có sự hiện diện của các hợp chất như flavonoid, saponin, tanin. Kết quả này tương ứng với nghiên cứu của Puguh (2014). Theo Puguh (2014) dịch chiết lá Trứng cá có hàm lượng cao phenol cao như flavonoid, tanin, polyphenol.
Flavonoid: là chất có cấu tạo khung kiểu C6-C3-C6. Flavonoid được biết là chất có tác dụng hạ đường huyết và phục hồi tế bào β của tuyến tụy, chống viêm, kháng khuẩn, kháng virus, chống dị ứng, điều trị các bệnh thoái hóa thần kinh, kháng oxy hóa (Harleen et al., 2011).
Saponin: trong tự nhiên nó thường tồn tại chủ yếu dạng vô định hình, hòa tan tốt trong cồn và nước, nhưng không hòa tan trong các dung môi hữu cơ không phân
cực như benzen và n-hexan. Saponin có vị đắng chát và vô cùng độc hại, vì chúng gây chứng thiếu máu tán huyết. Tuy nhiên, ở một lượng nhỏ, dịch chiết thực vật chứa hợp chất saponin có khả năng ức chế sự gây viêm (Karr, 2007).
Tanin: đặc trưng bởi vị đắng chát do đó những dịch chiết từ cây có tanin luôn có những vị này. Ngoài ra, hợp chất tanin có khả năng kháng E. coli và những vi khuẩn Gram dương gây hại là một đặc tính nổi bật của tanin (Kunwar, 2010). Tanin có nhiều hiệu quả sinh học cao như khả năng chống oxy hóa, kháng khuẩn, kháng virus, chống đột biến, chống đái tháo đường và có vai trò quan trọng trong việc ngăn ngừa bệnh mãn tính.
Khả năng kháng khuẩn của cao chiết ethanol lá trứng cá là do chứa hợp chất flavonoid, tanin, saponin. Theo Cushine và Andrew (2005) hầu hết các hợp chất flavonoid có tác dụng kháng khuẩn do: kiềm hãm và ngăn sự phân chia của vi khuẩn, ức chế enzym transpeptid ngăn quá trình tổng hợp mucopeptid (yếu tố tạo nên sự bền vững thành vi khuẩn), khi gắn lên màng vi khuẩn làm cho thay đổi tính thấm của màng, ức chế quá trình tổng hợp acid nucleic và RNA của vi khuẩn và ức chế sự hoạt động của hyaluronidase (enzym giúp cho vi khuẩn tấn công sang các tế bào lân cận). Bên cạnh đó các vòng carbon 6 cạnh có gắn các nhóm OH cũng gây ảnh hưởng đến thành tế bào vi khuẩn. Các nhóm hợp chất này sẽ xuyên qua thành tế bào vi khuẩn sau đó bám chặt vào những cấu trúc ở kích thước phân tử trong tế bào vi sinh vật như protein và glycoprotein, điều này làm rối loạn quá trình sinh tổng hợp của các vi sinh vật đó gây chết vi sinh vật (Immin, 2006). Bên cạnh đó hợp chất tanin có khả năng kháng những vi khuẩn Gram dương gây hại là một đặc tính nổi bật của tanin (Kunwar, 2010).
CHƯƠNG 5 KẾT LUẬN VÀ ĐỀ NGHỊ
5.1. KẾT LUẬN
- Bốn bộ phận cây Trứng cá lá, vỏ thân, quả chín và quả non chiết suất bằng phương pháp đun hồi lưu với dung môi ethanol 96 % hiệu suất chiết thu được lần lượt là 43,34
%; 33,27 %; 34,05 %; 24,82 %.
- Các loại cao chiết từ cây Trứng cá đều có khả năng ức chế dòng vi khuẩn 134N P. acnes. Trong đó cao chiết từ lá Trứng cá cho thấy hiệu quả kháng khuẩn cao nhất trong 4 loại cao với đường kính khoảng vô khuẩn dao động ở 3 nồng độ 50 mg/ml, 100 mg/ml, 200 mg/ml từ 16,33 mm đến 23 mm.
- Nồng độ MIC cao chiết lá trứng cá đối với dòng vi khuẩn 134N là MIC = 10 mg/ml.
- Cao chiết ethanol từ lá trứng cá có chứa các hợp chất flavonoid, saponin và tanin. Khả năng kháng khuẩn của cao chiết ethanol lá Trứng cá là do chứa hợp chất flavonoid, tanin, saponin.
5.2. ĐỀ NGHỊ
Nghiên cứu các yếu tố ảnh hưởng đến quá trình chiết xuất cây Trứng cá để gia tăng hiệu suất chiết.
Nghiên cứu chiết xuất các phân đoạn từ lá Trứng cá và khảo sát khả năng kháng vi khuẩn Propionibacterium acnes của các cao phân đoạn.
Phân lập các hợp chất tinh khiết cho khả năng kháng khuẩn tốt nhất từ lá Trứng cá từ đó làm tiền đề cho quá trình nghiên cứu và sản xuất dược phẩm có khả năng điều trị bệnh trứng cá.








